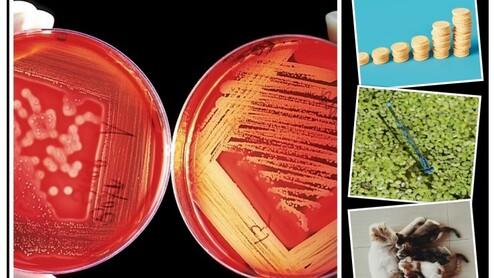

Mathematik
"Alles, was zählt"
Mathematik ist Basis aller Naturwissenschaften und fast jeder technischen Entwicklung. Sie spielt eine zentrale Rolle in der Wirtschaft und begleitet uns oftmals unbemerkt im Alltag: Vom Automobilbau bis zum Einkauf im Supermarkt, vom Wetterbericht bis zum Navigationssystem, vom Sport bis zum PC-Spiel - alles ist (auch) Mathematik. Keine anderes Fach ist derart präsent in allen unseren Lebensbereichen.
Mathematik ist also weit mehr als einfaches Herumrechnen mit ein paar Zahlen und fast jedes mathematische Prinzip ist mit einem spannenden Bereiche aus dem Alltag verknüpft. Es ist daher umso wichtiger zu verstehen, welche Rolle die Mathematik in der Welt spielt und wie man sie selbst benutzen kann, um Probleme zu lösen und sich Urteile zu bilden.
Das ist auch das Ziel des Mathematik-Unterrichts am Freiherr-vom-Stein-Gymnasium. Dazu lernen die Schülerinnen und Schüler schrittweise die verschiedenen Bereiche der Mathematik kennen: Arithmetik/Algebra, Funktionen, Statistik, Stochastik und vieles mehr.
Stundentafel Mathematik am Freiherr-vom-Stein-Gymnasium
Am FvS ist jedem Hauptfach (M, D, E, 2.FS) im Ganztagsbetrieb eine Stunde Lernzeit zugeordnet, die vom jeweiligen Fachlehrer betreut wird.
| Jahrgang | Anzahl Stunden Mathematik-Unterricht |
|---|---|
| 5 | 4 h + 1 h Lernzeit + 1 h Förder-/Forderunterricht |
| 6 | 4 h + 1 h Lernzeit |
| 7 | 4 h + 1 h Lernzeit |
| 8 | 4 h + 1 h Lernzeit |
| 9 | 3 h + 1 h Lernzeit |
| 10 | 3 h + 1 h Lernzeit |
| EF | 3 h + ggf. 2 h Vertiefungskurs |
| Q1 | 3 h Grundkurs oder 5 h Leistungskurs |
| Q2 | 3 h Grundkurs oder 5 h Leistungskurs |
... und wie sehen das die Schülerinnen und Schüler?
Den Mathe-Unterricht am FvS finde ich so gut, weil auf jeden mit seinen Schwächen und Stärken eingegangen wird und so auch jeder Spaß haben kann. Außerdem werden die Themen spannend gestaltet und wir dürfen auch in selbst zusammengestellten Gruppen Plakate entwerfen, so wird es auch nie langweilig.
(Ophelia, 7. Kl.)
Ich persönlich finde den Matheunterricht sehr interessant gestaltet. Für Kinder, die großes Interesse an Mathe haben, ist es kein Problem sich zu konzentrieren und mitzuarbeiten. Uns wird nicht immer alles erklärt und wir sollen es abspeichern und verwenden, sondern wir bekommen die Gelegenheit, selbst die Regeln oder die Funktion herauszufinden. Natürlich hängt die Gestaltung vom Lehrer ab. Aber wir können den Unterricht selbst interessant gestalten, indem wir uns beteiligen. Es macht dann viel mehr Spaß! Auch wenn ich nicht so gut mit Zahlen klarkomme, der Unterricht wird auch bildlich gestaltet. Das hilft mir persönlich sehr. Als Gesamtbild finde ich den Mathe-Unterricht am FvS sehr interessant.
(Victoria, 7. Kl.)
Und hier ein Statement zum Schmunzeln:
Mathe-Unterricht am FvS finde ich mega leicht, weil sich die Lehrer Mühe geben, den Unterricht schön zu gestalten und sehr nett sind. Außerdem genau geguckt wird, welche Schwächen wir verstärken können! ?
(ohne Namen)